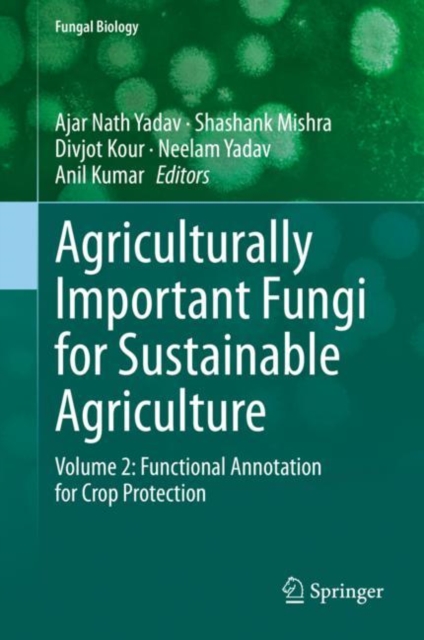
Agriculturally Important Fungi for Sustainable Agriculture

Agriculturally Important Fungi for Sustainable Agriculture
Microbes are ubiquitous in nature. Among microbes, fungal communities play an important role in agriculture, the environment, and medicine. Vast fungal diversity has been found in plant systems. The fungi associated with any plant system are in the form of epiphytic, endophytic, and rhizospheric fungi. These associated fungi play important roles in plant growth, crop yield, and soil health.
The rhi...
Microbes are ubiquitous in nature. Among microbes, fungal communities play an important role in agriculture, the environment, and medicine. Vast fungal diversity has been found in plant systems. The fungi associated with any plant system are in the form of epiphytic, endophytic, and rhizospheric fungi. These associated fungi play important roles in plant growth, crop yield, and soil health.
The rhi...